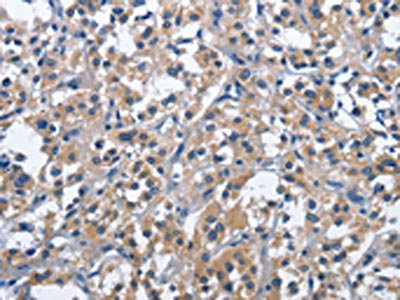

CD244 Antibody
-
中文名稱:CD244兔多克隆抗體
-
貨號:CSB-PA100599
-
規格:¥1100
-
圖片:
-
其他:
產品詳情
-
Uniprot No.:
-
基因名:
-
別名:2B4 antibody; C9.1 antibody; CD244 antibody; CD244 antigen antibody; CD244 molecule antibody; CD244 molecule natural killer cell receptor 2B4 antibody; CD244 natural killer cell receptor 2B4 antibody; CD244_HUMAN antibody; F730046O15Rik antibody; h2B4 antibody; Ly90 antibody; NAIL antibody; Natural killer cell activation-inducing ligand antibody; Natural killer cell receptor 2B4 antibody; NK cell activation inducing ligand antibody; NK cell activation inducing ligand NAIL antibody; NK cell activation-inducing ligand antibody; NK cell type I receptor protein 2B4 antibody; NKR2B4 antibody; Nmrk antibody; Non-MHC restricted killing associated antibody; OTTHUMP00000027884 antibody; p38 antibody; signaling lymphocytic activation molecule 4 antibody; SLAM family, member 4 antibody; SLAMF4 antibody
-
宿主:Rabbit
-
反應種屬:Human
-
免疫原:Fusion protein of Human CD244
-
免疫原種屬:Homo sapiens (Human)
-
標記方式:Non-conjugated
-
抗體亞型:IgG
-
純化方式:Antigen affinity purification
-
濃度:It differs from different batches. Please contact us to confirm it.
-
保存緩沖液:-20°C, pH7.4 PBS, 0.05% NaN3, 40% Glycerol
-
產品提供形式:Liquid
-
應用范圍:ELISA,IHC
-
推薦稀釋比:
Application Recommended Dilution ELISA 1:1000-1:2000 IHC 1:25-1:100 -
Protocols:
-
儲存條件:Upon receipt, store at -20°C or -80°C. Avoid repeated freeze.
-
貨期:Basically, we can dispatch the products out in 1-3 working days after receiving your orders. Delivery time maybe differs from different purchasing way or location, please kindly consult your local distributors for specific delivery time.
-
用途:For Research Use Only. Not for use in diagnostic or therapeutic procedures.
相關產品
靶點詳情
-
功能:Heterophilic receptor of the signaling lymphocytic activation molecule (SLAM) family; its ligand is CD48. SLAM receptors triggered by homo- or heterotypic cell-cell interactions are modulating the activation and differentiation of a wide variety of immune cells and thus are involved in the regulation and interconnection of both innate and adaptive immune response. Activities are controlled by presence or absence of small cytoplasmic adapter proteins, SH2D1A/SAP and/or SH2D1B/EAT-2. Acts as activating natural killer (NK) cell receptor. Activating function implicates association with SH2D1A and FYN. Downstreaming signaling involves predominantly VAV1, and, to a lesser degree, INPP5D/SHIP1 and CBL. Signal attenuation in the absence of SH2D1A is proposed to be dependent on INPP5D and to a lesser extent PTPN6/SHP-1 and PTPN11/SHP-2. Stimulates NK cell cytotoxicity, production of IFN-gamma and granule exocytosis. Optimal expansion and activation of NK cells seems to be dependent on the engagement of CD244 with CD48 expressed on neighboring NK cells. Acts as costimulator in NK activation by enhancing signals by other NK receptors such as NCR3 and NCR1. At early stages of NK cell differentiation may function as an inhibitory receptor possibly ensuring the self-tolerance of developing NK cells. Involved in the regulation of CD8(+) T-cell proliferation; expression on activated T-cells and binding to CD488 provides costimulatory-like function for neighboring T-cells. Inhibits inflammatory responses in dendritic cells (DCs).
-
基因功能參考文獻:
- Sole engagement of NKG2D, 2B4 or DNAM-1 is insufficient for NF-kappaB activation. PMID: 27221592
- We determined a significantly lower expression of CD244 on monocytes in systemic lupus erythematosus patients compared to healthy controls. Furthermore, monocyte CD244 expression was negatively associated with several serum autoantibody titres. PMID: 28593610
- SLAMF4 is a marker of intestinal immune cells which contributes to the protection against enteric pathogens and whose expression is dependent on the presence of the gut microbiota PMID: 28341747
- The present study provides further insights into the role of the 2B4-CD48 interaction in the fine regulation of CD8(+) T-cell effector function upon antigenic stimulation. PMID: 26860368
- Data show that 2B4 not only can bind to CD48 in trans but also interacts with CD48 in cis by using the same binding interface. Also, the results demonstrated that constitutive phosphorylation of 2B4 occurs only in the presence of CD48, and that cis binding is sufficient to induce substantial levels of baseline phosphorylation. PMID: 27249817
- 2B4 expression is increased on CD4+ T cells in septic patients PMID: 28768726
- Self-iNKR(-) NK cells in X-linked lymphoproliferative disease 1 patients are functional even in resting conditions, suggesting a role of the inhibitory 2B4/CD48 pathway in the education process during NK-cell maturation. PMID: 28386908
- our results provide strong evidence that CD244 co-operates with c-Kit to regulate leukemogenesis through SHP-2/p27 signaling. PMID: 28126968
- SLAMF4 gene and surface protein expression was down-regulated in CD8+ T cells from SLE patients compared with that in cells obtained from healthy donors. SLAMF4+ effector memory cells produced more granzyme B and perforin than SLAMF4- cells. PMID: 26314831
- GSK-3 undergoes inhibitory phosphorylation at regulatory serine residues by the engagement of NKG2D and 2B4, either individually or in combination. PMID: 26022178
- Cytomegalovirus-Induced Expression of CD244 after Liver Transplantation Is Associated with CD8+ T Cell Hyporesponsiveness to Alloantigen PMID: 26170387
- CD8(+) T cells require 2B4 for Epstein-Barr virus-specific immune control, because 2B4 blockade after CD8(+) T-cell depletion did not further aggravate symptoms of the infection. PMID: 25722295
- CD244 expression/signaling in tuberculosis correlates with high levels of a long noncoding RNA (lncRNA)-BC050410 [named as lncRNA-AS-GSTT1(1-72) or lncRNA-CD244] in the CD244(+)CD8(+) T-cell subpopulation. PMID: 26150504
- show that in addition to NKG2D, human CEACAM1 can inhibit NK-cell activation via NKp30 or 2B4 PMID: 25824372
- this study investigates the structural requirements for the recruitment of the human-activating NK-cell receptors NKG2D and 2B4 to detergent-resistant membrane fractions in the murine BA/F3 cell line and in the human NK-cell line NKL. PMID: 25545687
- Study of SAP expression is specific but may have insufficient sensitivity for screening XLP1 as a single tool; however, combination with 2B4 functional assay allows identification of all cases PMID: 24985396
- Blockade of 2B4/CD48 interaction resulted in improvement in function via perforin expression and degranulation as measured by CD107a surface mobilization on HTLV-1 specific CD8+ T cells. PMID: 24505299
- In patients suffering from X-linked lymphoproliferative disease (XLP1), SAP is nonfunctional, not only abolishing the activating function of 2B4, but rendering this receptor inhibitory. PMID: 24659462
- XLP1 inhibitory effect by 2B4 does not affect DNAM-1 and NKG2D activating pathways in NK cells. PMID: 24496997
- Our results indicate that rapid CD244 internalization is induced by a two-signal mechanism and plays a role in modulation of antiviral CD8 T cell responses PMID: 23913963
- data describe immune escape mechanism of monoclonal gammopathy/multiple myeloma occuring via downregulation of 3 major activating NK receptors (NCR3/NKp30, NKG2D and CD244/2B4/p38) in bone marrow, that was undetectable in peripheral blood. PMID: 23360454
- Monocyte-induced natural killer cell dysfunction was markedly attenuated by blocking CD48 receptor 2B4 on NK cells, but not by blockade of NKG2D and NKp30. PMID: 23225218
- TGF-beta1 may reduce the expression of NKG2D/DAP10 and 2B4/SAPin patients with hepatitis B. PMID: 22438812
- These results identify a novel role for 2B4 molecules in eosinophil functional migratory response and may point to a novel tyrosine kinase-mediated ligation between CCR3 receptor and 2B4 co-receptor in eosinophil chemotaxis. PMID: 22230401
- 2B4 is an important molecule within the network of costimulatory/inhibitory receptors regulating CD8+ T cell function in acute and chronic hepatitis C and 2B4 expression levels could also be a marker of CD8+ T cell dysfunction. PMID: 21625589
- The results obtained through a cohort of European Caucasian Systemic sclerosis patients do not support the implication of CD244 gene in the pathogenesis of SSc but the gene were identified as Rheumatoid arthritis susceptibility gene. PMID: 21586211
- glycosylation has an important impact on 2B4-mediated NK cell function and suggest that regulated changes in glycosylation during NK cell development and activation PMID: 21606496
- These results suggest a potential physical association between 2B4 and the ITAM receptor complexes that is required for 2B4-initiated signaling and cell-mediated killing. PMID: 21439641
- Data show that an increase in 2B4-expressing NK cells and a decrease in NKp46(+) NK cells occurred following intramuscular influenza vaccination. PMID: 21214542
- Engagement of the activating natural killer (NK) cell receptor 2B4 rapidly mediates an increase in the force necessary to separate NK cells from tumor cells. PMID: 21270395
- analysis of the importance of homotypic NK-to-NK cell cross-talk through 2B4/CD48 and CD2/CD58 pairs and further present their differential and overlapping roles in human NK cells PMID: 20813844
- Single nucleotide polymorphisms of CD244 gene predispose to renal and neuro-psychiatric manifestations with systemic lupus erythematosus. PMID: 20437071
- CD244 and PD-1 are highly coexpressed on virus-specific CD8+ T-cells in chronic HBV infection and blocking CD244 or its ligand CD48 may restore T-cell function independent of the PD-1 pathway. PMID: 21064032
- Single nucleotide polymorphism in CD244 gene is associated with rheumatoid arthritis. PMID: 18794858
- altered expression of splice variants of CS1 and 2B4 that mediate differential signalling in PBMC from patients with SLE. PMID: 20345977
- Major histocompatibility class (MHC) I proteins expressed on natural killer (NK) cells inhibit NKR2B4 receptor self-killing not only by serving as an inhibitory ligand for inhibitory NK receptors but also through the association with 2B4. PMID: 20164429
- Data show that pair-wise ligations of 2B4 with DNAM-1 and/or NKG2D lead to increased effector functions of primary CD4(+)CD28(-) T cells to suboptimal levels of anti-CD3 stimulation. PMID: 19904767
- Up-regulation of the activatory receptor 2B4 by CD8+ alpha beta T cells in vivo correlates with the acquisition of effector cell properties such as granzyme B and perforin expression, IFN-gamma production, and down-regulation of chemokine receptor CCR7. PMID: 11714776
- 2B4-mediated activation of natural killer cells involves the complex interactions of LAT, Ras, Raf, ERK and p38 kinase in the regulation of lytic function and cytokine production. PMID: 11714782
- X-linked lymphoproliferative disease causes impaired 2b4 function in NK cells. PMID: 11774610
- expressed on CD3+/CD56+ large granular lymphocytes proliferating in response to a tumor-expressed activating ligand (CD48) and killing autologous leukemia cells by a novel mechanism in a patient with acute myeloid leukemia. PMID: 11986947
- Natural killer cell inhibitory receptors block actin cytoskeleton-dependent recruitment of 2B4 (CD244) to lipid rafts. PMID: 12515815
- engagement of 2B4 on NK cells triggered a tyrosine phosphorylation signal PMID: 15169881
- expression significantly up-regulated on CD4 and CD8 T cells during infectious mononucleosis, and significantly more lymphocytes expressing CD8 and CD244/CD8 in patients with severe sore throat. PMID: 15195244
- The function of 2B4 as an adhesion molecule is underscored and a relevant role is suggested in the initial binding, scanning of target cells, and formation of cytotoxic natural killer cell immune synapse. PMID: 15356108
- the SAP/2B4 pathway plays a key role in CTL lytic activity against EBV-positive targets by promoting the polarization of the lytic machinery PMID: 15677558
- analysis of the molecular basis for the different signals generated by 2B4 PMID: 15713798
- Functional analysis indicates that Lys-68 and Glu-70 in the extracellular domain of human 2B4 play a key role in the activation of human natural killer (NK) cells through 2B4/CD48 interaction. PMID: 16002700
- Review of recent studies suggests an important role for interactions between 2B4 and CD48 in the course of T cell activation and proliferation PMID: 16081768
- CD244-3BP2 association regulates cytolytic function but not IFN-gamma release PMID: 16177062
顯示更多
收起更多
-
亞細胞定位:Membrane; Single-pass type I membrane protein. Cell membrane.
-
組織特異性:Expressed in spleen, PBL, followed by lung, liver, testis and small intestine. Expressed in all natural killer (NK) cells, monocytes and basophils, TCR-gamma/delta+ T-cells, monocytes, basophils, and on a subset of CD8(+) T-cells.
-
數據庫鏈接:
Most popular with customers
-
-
YWHAB Recombinant Monoclonal Antibody
Applications: ELISA, WB, IHC, IF, FC
Species Reactivity: Human, Mouse, Rat
-
Phospho-YAP1 (S127) Recombinant Monoclonal Antibody
Applications: ELISA, WB, IHC
Species Reactivity: Human
-
-
-
-
-